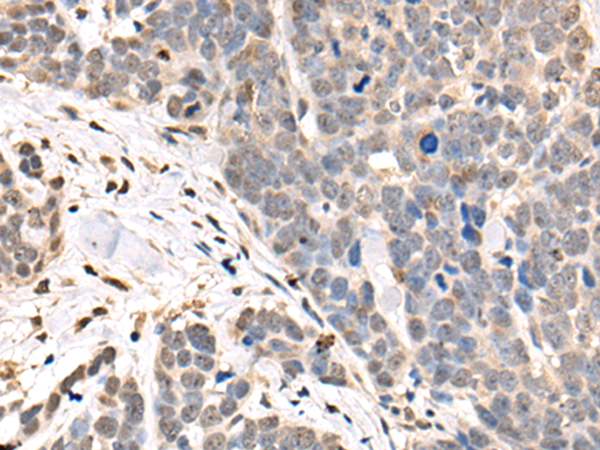

-
分类: 科研抗体货号: P09323别名: UP3A; UPK3; UPIII; UPIIIA应用: IHC反应种属: Human, Mouse
-
分类: 科研抗体货号: P09301别名:应用: IHC反应种属: Human, Mouse
-
分类: 科研抗体货号: P09343别名:应用: IHC反应种属: Human, Mouse
-
分类: 科研抗体货号: P09322别名: QPC; QCR8; QP-C; UQCR7; MC3DN4应用: WB,IHC反应种属: Human, Rat
-
分类: 科研抗体货号: P09336别名: ASXH2应用: IHC反应种属: Human, Mouse
-
分类: 科研抗体货号: P09342别名: ATP5C; ATP5C1; ATP5CL1应用: WB,IHC反应种属: Human, Mouse, Rat
-
分类: 科研抗体货号: P09321别名: UNC5H3应用: WB反应种属: Human, Mouse, Rat
-
分类: 科研抗体货号: P09335别名: ASS; CTLN1应用: WB,IHC反应种属: Human, Mouse, Rat
-
分类: 科研抗体货号: P09341别名: HSN1F应用: WB,IHC反应种属: Human, Mouse, Rat
-
分类: 科研抗体货号: P09319别名: UNC13; MUNC13; Unc13h2; munc13-2应用: IHC反应种属: Human, Mouse, Rat

鄂公网安备42018502007531号
鄂公网安备42018502007531号

